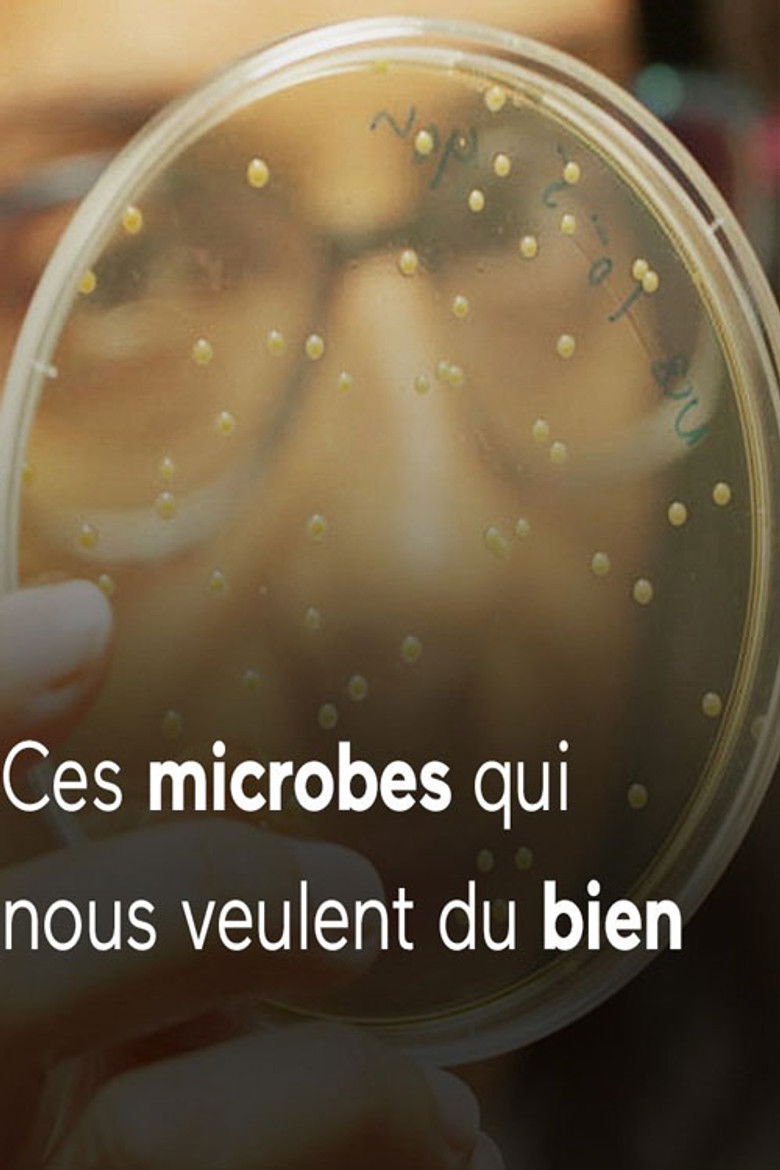

| Release Date | — | |
|---|---|---|
| Status | Released | |
| Original Title | Ces microbes qui vous veulent du bien | |
| Runtime | — | |
| Budget | — | |
| Revenue | — | |
| Language | — | |
| Original Language | French | |
| Production Countries | — | |
| Production Companies | ||
| Release Date | — | |
|---|---|---|
| Status | Released | |
| Original Title | Ces microbes qui vous veulent du bien | |
| Runtime | — | |
| Budget | — | |
| Revenue | — | |
| Language | — | |
| Original Language | French | |
| Production Countries | — | |
| Production Companies | ||